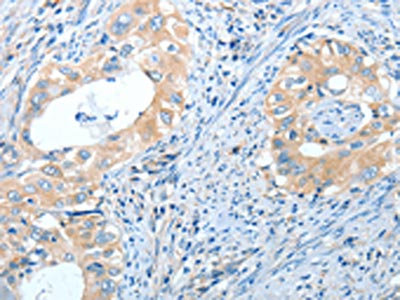

IL13RA2 Antibody
-
中文名稱:IL13RA2兔多克隆抗體
-
貨號:CSB-PA239289
-
規格:¥1100
-
圖片:
-
The image on the left is immunohistochemistry of paraffin-embedded Human lymphoma tissue using CSB-PA239289(IL13RA2 Antibody) at dilution 1/30, on the right is treated with fusion protein. (Original magnification: ×200)
-
The image on the left is immunohistochemistry of paraffin-embedded Human cervical cancer tissue using CSB-PA239289(IL13RA2 Antibody) at dilution 1/30, on the right is treated with fusion protein. (Original magnification: ×200)
-
-
其他:
產品詳情
-
Uniprot No.:
-
基因名:
-
別名:Cancer/testis antigen 19 antibody; CD213a2 antibody; CT19 antibody; I13R2_HUMAN antibody; IL-13 receptor subunit alpha-2 antibody; IL-13R subunit alpha-2 antibody; IL-13R-alpha-2 antibody; IL-13RA2 antibody; IL13 receptor antibody; IL13BP antibody; IL13R antibody; Il13ra2 antibody; Interleukin 13 binding protein antibody; Interleukin 13 receptor alpha 2 chain antibody; Interleukin-13 receptor subunit alpha-2 antibody; Interleukin-13-binding protein antibody
-
宿主:Rabbit
-
反應種屬:Human
-
免疫原:Fusion protein of Human IL13RA2
-
免疫原種屬:Homo sapiens (Human)
-
標記方式:Non-conjugated
-
抗體亞型:IgG
-
純化方式:Antigen affinity purification
-
濃度:It differs from different batches. Please contact us to confirm it.
-
保存緩沖液:-20°C, pH7.4 PBS, 0.05% NaN3, 40% Glycerol
-
產品提供形式:Liquid
-
應用范圍:ELISA,IHC
-
推薦稀釋比:
Application Recommended Dilution ELISA 1:1000-1:2000 IHC 1:15-1:50 -
Protocols:
-
儲存條件:Upon receipt, store at -20°C or -80°C. Avoid repeated freeze.
-
貨期:Basically, we can dispatch the products out in 1-3 working days after receiving your orders. Delivery time maybe differs from different purchasing way or location, please kindly consult your local distributors for specific delivery time.
-
用途:For Research Use Only. Not for use in diagnostic or therapeutic procedures.
相關產品
靶點詳情
-
功能:Binds as a monomer with high affinity to interleukin-13 (IL13), but not to interleukin-4 (IL4).
-
基因功能參考文獻:
- this study shows that tricellulin is regulated via interleukin-13-receptor alpha2, affects macromolecule uptake, and is decreased in ulcerative colitis PMID: 28612843
- IL-13Ralpha2 alone induces invasiveness of human glioblastoma multiforme (GBM) cells without affecting their proliferation. In contrast, in the presence of the mutant EGFR (EGFRvIII), IL-13Ralpha2 promotes GBM cell proliferation in vitro and in vivo. PMID: 29203859
- The results showed that IL13Ralpha2 may be used as a marker of poorer prognosis in high-grade astrocytomas, even among tumors of the same grade. PMID: 28079349
- TMEM219 plays a critical role in Chi3l1-induced IL-13Ralpha2 mediated signalling and tissue responses. PMID: 27629921
- This study shows interleukin-13 receptor alpha 2 expression could be a useful prognostic marker for selecting patients with luminal breast cancer likely to follow a clinically aggressive course despite receiving systemic therapy. PMID: 29911489
- Transgenic expression of IL15 is an appealing strategy to enhance CAR T-cell effector function. We tested this approach in our IL13Ralpha2-positive glioma model in which limited IL13Ralpha2-CAR T-cell persistence results in recurrence of antigen-positive gliomas. T cells were genetically modified with retroviral vectors encoding IL13Ralpha2-CARs or IL15 (IL13Ralpha2-CAR.IL15 T cells). PMID: 28550091
- IL-13Ralpha2 may have a role in decreased overall survival in gastric cancer after gastrectomy PMID: 27351230
- cigarette smoke extracts activate the PKA, CREB, and IL-13Ralpha2 axis in lung endothelial cells. PMID: 27986643
- High expression of IL-13Ra2 is significantly associated with the growth and metastasis of glioma cells via the Scr/PI3K/Akt/mTOR pathway. PMID: 27623944
- Data indicate single-chain antibody (scFv47) as a highly selective interleukin 13 receptor subunit alpha 2 (IL13Ralpha2) targeting agent. PMID: 26656559
- IL13Ralpha2 knockdown and IL-13 treatment cooperatively upregulated the metastasis suppressor tumor protein 63 (TP63) in a STAT6-dependent manner. PMID: 26208975
- Expression of CXCR3 in fibroblasts is associated with the expression of IL-13Ralpha2. PMID: 25514189
- In this review, we will discuss the recent advances in the IL13Ralpha2-targeted immunotherapy and evaluate the most promising strategy for targeted GBM immunotherapy. [review] PMID: 25247196
- Study presents evidence that PNR could promote ERalpha-negative breast cancer metastasis through activation of IL-13Ralpha2-mediated signaling pathway. PMID: 24747967
- In cytotoxicity assays, CAR T cells killed CAR T cells killed IL13Ra1- and/or IL13Ra2-positive cells in contrast to IL13Ra1- and IL13Ra2-negative controls PMID: 24841514
- IL13Ralpha2 over-expression is associated with glioma. PMID: 24204956
- Expression of IL-13Ralpha2 in tumors was significantly decreased with IL-13-PE treatment as compared to the controls and the number of myeloid-derived suppressor cells (MDSC) was also significantly reduced in the spleens of the IL-13-PE treated mice PMID: 23421960
- high expression of IL-13Ralpha2 was associated with later stages of disease progression and poor outcome in patients with colorectal cancer PMID: 22505647
- IL-13RALPHA2 is involved in cancer metastasis through activation of ERK/AP-1 PMID: 21858811
- expression of IL-13Ralpha2 prevents apoptosis and contributes to tumor growth. PMID: 21596889
- A novel function of histone modification in the regulation of IL-13Ralpha2 in pancreatic cancer cell lines in vitro and in vivo, was identified. PMID: 21477288
- Cells with high IL-13Ralpha2 expression rapidly and efficiently deplete extracellular IL-13 and could have important implications for the design and characterization of IL-13 antagonists. PMID: 21622864
- IL-13Ralpha2 may be an important endogenous regulator of IL-13-induced cutaneous inflammation in humans. PMID: 20971924
- The expression level of IL-13Ralpha2 was significantly reduced in first-recurrent glioblastomas (frGBMs) compared to primary GBMs, and significantly reduced in all untreated malignant astrocytomas compared with treated frGBMs. PMID: 20805641
- In eosinophil lineage-deficient IL-13 transgenic mice with eosinophilic esophagitis, IL-13-induced remodeling is significantly enhanced by IL-13Ralpha2 deletion, indicating an inhibitory effect of IL-13Ralpha2. PMID: 20543112
- IL-13Ralpha2-positive tumors were targeted by IL-13PE cytotoxin in vitro and in vivo in an orthotopic murine model of human pancreatic cancer. PMID: 20068108
- Soluble IL-13R2alpha and membrane IL-13R2alpha isoforms are both derived from the membrane form of the human receptor. An alternatively spliced sIL-13R2alpha transcript is absent in humans, compared with mice. PMID: 20007572
- IL-13Ralpha(345-354) (WLPFGFILI) induced a CD8(+) T-cell line that specifically produced IFN-gamma in response to HLA-A2+ T2 cells pulsed with the relevant peptide and lysed these cells. PMID: 12231526
- interleukin-13 receptor possibly plays an important part in the early inflammatory process of psoriasis; however, its function is lost in the psoriatic keratinocytes. PMID: 12445201
- IL-4/IL-13-induced IL-13Ralpha2 expression is potentiated by TNF-alpha PMID: 12485861
- The 5' flanking region of IL-13Ra2 has been isolated and cloned and the gene control region functionally characterized. PMID: 12816724
- The inhibitory effects of the IL-13 receptor alpha 2 subunit on IL-13 signaling are dependent on both the level of expression of the receptor and the concentration of IL-13. PMID: 16751396
- Immunohistochemical analyses revealed that 83% of ovarian cancer specimens express IL-13Ralpha2, whereas normal ovary samples expressed none or very low levels. PMID: 16902988
- data suggest that IL13RA2 gene polymorphisms may be involved in susceptibility to systemic sclerosis PMID: 16981293
- Highly variable expression of IL13Ralpha2 protein both within and across specimens of glioblastoma multiforme. PMID: 17804706
- IL-13Ralpha2 and Olig2 have been identified and confirmed to be interesting candidate genes whose differential expression likely plays a role in malignant progression of astrocytomas PMID: 17917751
- RasGRP4 translocates to varied intracellular compartments via its DAG/PMA-binding domain to regulate signaling pathways that control gene and protein expression in MCs, including the cell's ability to respond to IL-13. PMID: 18024961
- soluble form of IL-13Ralpha(2) may therefore modulate mucus overproduction by IL-13 through the pathway including IL-13Ralpha(1) in normal human bronchial epithelial cells PMID: 18028464
- IL-13R alpha 2, EphA2, and Fra-1 are attractive therapeutic targets representing molecular denominators of high-grade astrocytomas. One hundred percent of GBM tumors overexpress at least one of these proteins. PMID: 18172271
- 13Ralpha2 protein and mRNA are expressed to significantly higher levels in brainstem glioma than in normal brain tissue PMID: 18430795
- The feasibility of MRI to visualize different phases of immune response when IL-13Ralpha2-specific CTLs are administered directly to the glioma tumor bed. PMID: 18559603
- IL-13Ralpha2 is expressed by both primary bronchial epithelial cells and fibroblasts as an intracellular protein with a diffuse cytoplasmic distribution; in vivo, IL-13Ralpha2 is expressed in the airway mucosa mainly by bronchial epithelial cells PMID: 18564628
- analysis of cDNA clone and prokaryotic expression of human interleukin-13 receptor [alpha]2 chain PMID: 18677476
- study concludes that matrix metalloproteinase-8 cleaves IL-13R alpha 2 in vitro and contributes to the solubilization of IL-13R alpha 2 in vivo PMID: 18694590
- Hepatic stellate cells in sinusoidal lesions of liver from patients with nonalcoholic steatohepatitis express high levels of high-affinity IL-13R (IL-13 receptor alpha2), whereas fatty liver and normal liver specimens do not express IL-13Ralpha2. PMID: 18802068
- Human adrenomedullin up-regulates interleukin-13 receptor alpha2 chain in prostate cancer in vitro and in vivo. PMID: 19010904
- Cytokines IL-13Ralpha2, IL-4, IL-6, IL-8 and TNF-alpha may play roles in the pathogenesis of pediatric HSP/HSPN. PMID: 19149920
- Human and murine neuroendocrine pheochromocytoma overexpress the IL-13Ralpha2 chain, and an IL-13PE-based receptor-directed anticancer approach may prove useful in treatment for metastatic pheochromocytoma patients. PMID: 19491224
- IL-13Ralpha2 may serve as a prognostic biomarker of invasion and metastasis in pancreatic cancer. PMID: 19887609
- Humans only express the membrane bound form of the IL-13 receptor alpha 2 PMID: 18307523
顯示更多
收起更多
-
亞細胞定位:Membrane; Single-pass type I membrane protein.
-
蛋白家族:Type I cytokine receptor family, Type 5 subfamily
-
數據庫鏈接:
Most popular with customers
-
-
YWHAB Recombinant Monoclonal Antibody
Applications: ELISA, WB, IHC, IF, FC
Species Reactivity: Human, Mouse, Rat
-
Phospho-YAP1 (S127) Recombinant Monoclonal Antibody
Applications: ELISA, WB, IHC
Species Reactivity: Human
-
-
-
-
-